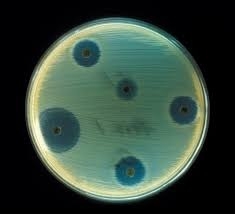

去年の暮れに、ウダツの現場で仕事をしてもらっている職人さんたちと、マカオに行ってきました。今、自分の周りに漂っている運が、上り調子なのか、そうでないのかを嗅ぎ分ける力を養う為に。ボクにとってマカオといえば、沢木耕太郎の深夜特急に描かれた刺激的な街です。マカオのカジノで「大小」というゲーム、これは3つのサイコロの合計が、大か小かに掛けるというもので、単純であるがゆえの奥深さのめり込み、旅費のすべてを失う寸前までやられて、その次の日に、ふとしたことからディーラーがサイコロを振る癖に気づいてから挽回を重ねてトントンまで巻き返し、結局なんとかその後の旅を続けることができたという物語がボクの心に深く刻まれていて、いつかはマカオのカジノで大小の世界に浸ってみたいと思っていたのでした。仕事がうまくいったり、いかなかったりする原泉は、自分の努力やスキルよりも運のほうが少しだけ大きいように思います。人と出会うこと、人が動いてくれたこと、物件を買うことができたこと、他者が気づかない物件のポテンシャルにちょっとしたキッカケで気づけたこと、いろいろあります。

カジノとは随分話がソレますが、ペニシリンの発見でノーベル賞をとったフレミング教授の話。ある金曜日に彼女とのデートに遅れそうになり、実験室のシャーレに蓋をするのを忘れて出てしまい、明けの月曜の朝、そのシャーレの中に発生したアオカビを見つけたことがキッカケとなり、ペニシリンの大発見につながった、と言われています。運命とはよく言ったものではありますが、日頃から自分のプロフェッショナル性を磨くための探求や、考えぬいた仕事を心がけて目を見開いていなければ、フレミングも青カビのシャーレをゴミ箱に捨てていたことと思います。
自分の仕事と運については、「ノッている時にグァーと行く判断ができるか?」また、「ノッてない時には、ガマンしながら再び運を呼び寄せるための行動ができるか?」そのさなかにいる時に状況を適切に判断できるのは、並大抵のことではありません。あとから見て評論するのは簡単なののに・・・というものだと思います。そこで、その運を見極める力を鍛えること、ちょっとした偶然からくる「違い」に気づく目を養う感性を鍛えてゆきたいものですね。ボクはこのような運気や偶然性を大事にしています。しかし、決して自己啓発セミナー、スピリチュアルなどにハマっているわけではありません。今、UDATSUの物件を買おうかどうか、検討されているお客様!変な会社ではありませんので、どうぞご安心くださいませ。